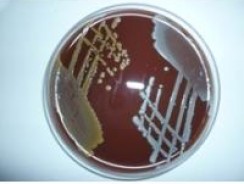

Menzies has been studying scabies and skin bacterial infections for over 3 decades. This includes various iterations of the NT Healthy Skin Program, which was initiated with the NT Department of Health. There have been formal and informal collaborations with colleagues across Australia and internationally. The guidelines for skin health developed by Menzies and NT health are used nationally and the specific guideline for crusted scabies is used internationally.
It is estimated that as many as 1 billion people are affected by skin disease across the world. The global burden of disease (GBD) study determined that skin disease affects as much as a third of the global population and is the fourth most common cause of disease in the world. Skin disease has been reported as one of the most common causes for presentation to rural and remote primary healthcare centres in Western Australia and the Northern Territory (NT).
Childhood skin infections such as skin sores/pyoderma/impetigo are predominantly bacterial infections and are usually caused by Group A Streptococcus and Staphylococcus bacteria. They are very common in many remote communities. As well as the local discomfort and effect on school attendance, they can also lead to serious secondary complications including potentially fatal sepsis and acute rheumatic fever, rheumatic heart disease and post-streptococcal glomerulonephritis.
Scabies is a skin disease which is endemic in northern Australia and is believed to be the underlying cause of up to 70 per cent of bacterial skin infections in Aboriginal and Torres Strait Islander communities in the NT. It is caused by the transmission of a parasitic mite which burrows under the skin after contact with an infected person and is estimated to affect up to 25 per cent of the population of remote communities. Scabies therefore contributes to the health and life expectancy gap that exists between Aboriginal and Torres Strait Islander people and other Australians. Scabies was added to the list of Neglected Tropical Diseases (NTD) in 2017, which has led to increased advocacy and representation on the global policy agenda.
Crusted scabies is a notifiable disease under the NT Notifiable Diseases Act (1981) and leprosy is nationally notifiable in Australia. Yaws is another skin-NTD which continues to be prevalent in the Pacific region but has been eliminated in Australia with no recent cases reported.
There is a strong rationale for recognising the NTDs with skin manifestations (skin-NTDs) together as a group: many conditions are co-endemic in the same geographical region, diagnostic and laboratory testing methods can often be shared and training methodology can be integrated to upskill local healthcare workers.
It is important that we encourage a collaborative focus on skin-NTDs in Australia, particularly as the burden of disease of some skin-NTDs in northern Australia is among the highest in the world and in line with the disease burden in developing nations. There should be a focus on promoting horizontal programs which streamline case detection and management using concurrent diagnostic and management pathways.